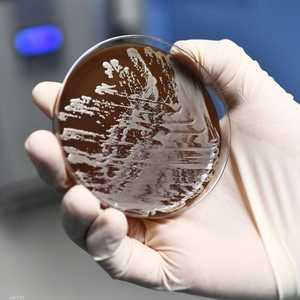
البكتيريا تلجأ لأسلوب التخفي وتغيير شكلها لخداع المضادات.

العالم يدق ناقوس خطر "مقاومة المضادات الحيوية"
21:48 - 13 نوفمبر 2021تنذر مقاومة المضادات الحيوية، والميكروبية بصفة عامة، بأزمة صحية عالمية لا تقل فتكا وخطرا عن فيروس كورونا المستجد، إذ من شأنها أن تجعل من أبسط الاصابات والجروح والالتهابات التي يسهل علاجها، أمراضا فتاكة.
وتقوم الميكروبات من الجراثيم والفيروسات والطفيليات عامة، بالتغير والتطور بشكل متواصل كي تضمن بقاءها، وتتكيف مع العلاجات واللقاحات المضادة لها، لدرجة تمكنها من تطوير مقاومة للمضادات، التي تغدو بلا تأثير علاجي، كما هو الحال مع المضادات الحيوية ضد البكتيريا.
ويجعل هذا من الصعب معالجة الأنواع الشائعة من العدوى، ويزيد من مخاطر انتشار الأمراض والاعتلالات الوخيمة والوفاة، بحسب منظمة الصحة العالمية.
ويطلق على قدرة الميكروبات على النجاة من الأدوية المستخدمة ضدها، تسمية "مقاومة مضادات الميكروبات"، وفي حال كان مسبب المرض عدوى بكتيرية، والتي تعد المضادات الحيوية الأدوية الأهم استخداما لعلاجها، عندها فنحن نتحدث عن مقاومة المضادات الحيوية.
ويستهدف الأسبوع العالمي للتوعية بشأن المضادات الحيوية ومضادات الميكروبات عامة، الارتقاء بالوعي حول ظاهرة مقاومة مضادات الميكروبات على الصعيد العالمي، وتشجيع عامة الجمهور والعاملين الصحيين وراسمي السياسات على اعتماد أفضل الممارسات، لتجنب استمرار ظهور حالات العدوى المقاومة للأدوية وانتشارها، وفق منظمة الصحة العالمية.
وكان قد تم اعتماد خطة عمل عالمية للتصدي للمشكلة المتنامية التي تطرحها مقاومة المضادات الحيوية والأدوية الأخرى المضادة للميكروبات، خلال انعقاد جمعية الصحة العالمية الثامنة والستين في مايو 2015.
ويتمثل أحد الأهداف الرئيسية للخطة، في زيادة الوعي بظاهرة مقاومة مضادات الميكروبات وفهمها بشكل أفضل، من خلال التواصل والتثقيف والتدريب بفعالية.
وفي أعقاب اجتماع تشاوري في مايو 2020، نظمه الثلاثي: منظمة الأغذية والزراعة للأمم المتحدة (الفاو)، والمنظمة العالمية لصحة الحيوان، ومنظمة الصحة العالمية، تقرر توسيع نطاق الأسبوع العالمي للتوعية بشأن مضادات الميكروبات، وتغيير محوره من المضادات الحيوية إلى المصطلح الجامع الشامل مضادات الميكروبات .
وسيسهم توسيع نطاق الحملة ليشمل جميع أنواع مضادات الميكروبات، في إرساء استجابة عالمية أشمل لمسألة مقاومة مضادات الميكروبات، ودعم نهج متعدد التخصصات قائم على مفهوم الصحة الواحدة.
وكانت اللجنة التنفيذية الثلاثية تلك قد قررت تحديد الفترة من 18 إلى 24 نوفمبر من كل عام للاحتفال بأسبوع التوعية، ابتداءً من عام 2020.
مخاوف
قبيل بدء فعاليات الأسبوع العالمي للتوعية بالمضادات الحيوية والميكروبية لهذا العام، تسود مخاوف جدية في الأوساط والمحافل الصحية والعلمية حول العالم، من أن تصبح مقاومة تلك المضادات، من أكبر التحديات الصحية في هذا القرن، خاصة وأن نسبة الوعي بهذه المشكلة الخطيرة والمتفاقمة متدنية للغاية، وهي مشكلة غير موثقة ومشخصة كما يجب في ظل غياب نظام عالمي لجمع البيانات وتحليلها.
وتذهب تقارير وتقديرات صحية أوروبية رسمية، إلى أنه بحلول عام 2050 قد يموت نحو 10 ملايين إنسان بسبب إصابات مقاومة للمضادات الحيوية، وهو رقم مهول يفسر تصاعد الحملات للتوعية بهذا الخطر الصحي الداهم، وبحث سبل تداركه عالميا.
وللحديث عن أهمية المضادات الحيوية وطرق استخدامها الصحيحة والمحاذير المتعلقة بتعاطيها، يقول مؤسس منصة الصحة السورية، الدكتور أحمد محمد، لموقع "سكاي نيوز عربية": "المضادات الحيوية هي نوع من الأدوية الموجهة لقتل الجراثيم، هدفها قتل كائنات حية دقيقة كالجراثيم، والتي تختلف عن الفيروسات، حيث هي ميتة ليست على قيد الحياة، كونها عبارة عن شريط DNA يتحول لمخلوق حي عندما يدخل جسم ما، كالجسم البشري ويتكاثر حينها".
وتابع: "بالتالي فالمضاد الحيوي هو بالتحديد ضد الكائن الحي الجرثومي، الذي هو على قيد الحياة حتى وهو خارج جسم الإنسان، بينما الفيروس لا يصبح حيا إلا بعد دخول الجسم".
ويوضح أن هذه المضادات اكتُشفت بالصدفة منذ زمن طويل عند تجريب البنسلين، الذي أعطى فعالية عالية ضد أحد أنواع الجراثيم المسببة للالتهابات.
ويضيف: "منذ ذلك الحين بدأ عصر المضادات الحيوية التي انتشرت على أوسع نطاق حول العالم، لقدرتها الفائقة على معالجة الالتهابات الجرثومية، وباتت تعرف كدواء سحري، إذ خلال يومين أو 3 تتمكن من مداواة الإصابات الجرثومية، التي كان قبلها يموت الكثير من المرضى جراء مضاعفات تلك الالتهابات".
ويستطرد الطبيب السوري: "لكن مع ذلك، فالجراثيم لديها قدرة ذكية على المراوغة، وهي أشبه بالإنسان الذي بعد تعرضه للصدمة عدة مرات، يصبح أكثر قدرة على امتصاصها واستيعابها، لدرجة أنها مع التكرار ومرور الوقت لا تؤثر فيه، كذلك الأمر بالنسبة للمضادات الحيوية، فعند الاستخدام المفرط والمستمر لها، تقل فعاليتها وتتلاشى وتتوقف الجراثيم عن التأثر بها".
ويشرح محمد آليات تشكيل المقاومة الجرثومية للمضادات الحيوية، بالقول: "الجراثيم تتبع 3 آليات للتغلب على المضادات ومحاربتها، فهي تلجأ أولا لإغلاق معابر دخول الدواء من الخارج لخلاياها، عبر التعرف عليه فتمنعه من المرور، وفي حال الفشل في ذلك تقوم بابتداع معابر جديدة للفظ الدواء وإخراجه من خلالها، وفي حالات ثالثة ورغم دخول المادة الدوائية المضادة لخلاياها، تبادر الجراثيم بإفراز مواد تعمل على إبطال فعالية الدواء".
ويتابع: "من المؤسف أن نعرف أننا بحاجة لعشرة أعوام كاملة، كي نتمكن من تطوير مضاد حيوي جديد، في الوقت الذي يطور فيه الجرثوم المقاومة للمضاد الحيوي خلال 10 أيام فقط، وهذا يكشف حجم المشكلة الصحية التي تواجه العالم وعمقها".
ومن الأخطاء الشائعة لدى الناس، أنه عند أدنى وجع في أجسادهم يبادرون فورا لتناول المضادات الحيوية كمسكن للألم، في حين أنها ليست من مسكنات الألم ولا تمت لها بصلة.
فاطمة الأطرقجي.. العراقية التي أسمعتنا صوت البكتريا

وفي هذا السياق، يقول محمد: "تعاطي المضادات دون وصفة طبية ينطوي على خطأين جسيمين، أولهما أن تعاطيها دون وجود التهابات جرثومية موجبة لها، يسهم في خلق المقاومة في الجسم لهذه المضادات، مما يقلل من فاعليتها وتأثيرها العلاجي والدوائي، بل بتعاطيها بهذا الشكل العشوائي هي تقتل بذلك الجراثيم المفيدة المستوطنة في جسم الإنسان، وقد ينجم عن ذلك حالات إسهال حادة قد تؤدي للوفاة".
ويحذر الطبيب من أنه في حال الاستمرار في تعاطيها دون الحاجة، فإنه "عندما يحتاج المريض المعني بالفعل لتعاطي المضادات الحيوية، فإنه لا يستفيد منها في حال إصابته بالتهابات جرثومية".
ويمضي في الشرح بالقول: "ثم هناك حقيقة أن جراثيم فلورا الموجودة في الأمعاء مفيدة لجسم الإنسان، ومستوطنة فيه بشكل طبيعي، والتناول الخاطئ للمضادات الحيوية يعمل على قتلها، ويتسبب تاليا بالإصابة بنوبات إسهال شديدة، والسبب أن الجراثيم المفيدة لم تعد قادرة على تفكيك الغذاء وتحليله بالشكل الصحيح، وبالتالي لا يستطيع الجسم الاستفادة منها كما يجب، مما قد ينجم عنه في المحصلة تطور سلبي للحالة المرضية، والإصابة بالإسهال والالتهاب الجرثومي الذي يهدد حياة الإنسان".
ويختم الدكتور محمد تصريحاته لموقع "سكاي نيوز عربية"، قائلا: "حربنا مع الجراثيم خاسرة مع الأسف، فبعد سنوات سيصبح أبسط التهاب كالتهاب اللوزتين مثلا قاتلا، ولن نكون قادرين على إيجاد مضادات مناسبة للقضاء عليها ومعالجتها، كون الجراثيم اكتسبت بمرور الزمن وسوء الاستخدام المناعة والمقاومة ضد المضادات الحيوية، ولا قدرة لدينا على تطوير مضادات جديدة إلا بعد سنوات".